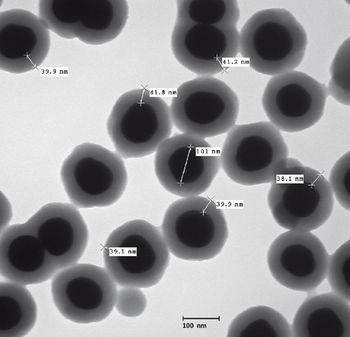
i4-600238-1408649369047.jpg

Recent developments in photonics are finally making Raman instrumentation accessible to larger basic laboratories.

Recent developments in photonics are finally making Raman instrumentation accessible to larger basic laboratories.

Today's Raman spectrometers are more capable than ever before. The seeds of innovation in filter, laser, and CCD technology have produced a crop of instruments that are fast, sensitive, and robust. This is good news because scientists are constantly bombarded with challenging problems that require the top performance from their instruments.

Surface-enhanced Raman spectroscopy (SERS) has been studied extensively over the last few decades with many advances in preparation of SERS substrates and coatings. While the bulk of the research in SERS substrate preparation has been devoted to pushing detection limits to higher sensitivity for measurement of single samples, the application of SERS to high-throughput analysis has been largely ignored. In this article, we present the use of commercially available SERS-coated microtiter plates in a dedicated Raman microtiter plate reader, enabling high-throughput trace analysis measurements. This article also describes the SERS substrate, the high-throughput plate reader, and preliminary results from samples representing trace analysis of explosives, nerve agents, pharmaceuticals, and biological compounds.

A better understanding of the micro- and nanostructures of cellulose fiber composition before and after various chemical treatments, together with the distribution of bleaching additives to the final paper composition, is essential for further improvements of paper properties. Confocal Raman imaging is a valuable tool for such studies, as it reveals not only optical information but also information regarding the 3D distribution of the chemical compounds in the submicrometer range. In the paper surface finishing process, additional surface roughness parameters can be measured by combining confocal Raman microscopy with atomic force microscopy. Such combined analytical microscopes allow a direct linking between high-resolution imaging and chemical identification of various species on a surface.

The use of explosive devices by terrorist groups has become a constant threat in recent years. Because of this threat, the U.S. Army and other organizations are developing spectroscopic techniques to detect explosives and perform forensic examination of scenes where explosives were handled. In our group, Raman chemical imaging (RCI) is being used for forensic examination of latent fingerprints contaminated with traces of explosives. RCI has the potential to be a powerful technique both for detecting explosives and providing the biometric information necessary to identify individuals who have handled explosives.

Interest in vibrational spectroscopy, principally Raman and mid-IR (FT-IR) continues to increase as these analytical techniques may be applied to a wide variety of fields, including the safety/security sector. Raman and FT-IR have seen rapid deployment for use in homeland security applications, largely due to the high chemical specificity which allows robust identification. In this article, we discuss the application of the latest portable, rugged Raman and FT-IR handhelds, enabling robust identification of explosives, TICs, TIMs, and narcotics in the field. This article introduces explosives, their different classes, and the applicability of Raman and FT-IR spectroscopy to identify their components (commercial, HMEs, and IEDs) or precursors.

Documents have been investigated to determine the feasibility of utilizing Raman and SERS Raman spectroscopy for the identification and characterization of inks on paper. Fluorescence reduction methods have been employed to facilitate the analysis by reducing the nascent fluorescence from paper and ink. Furthermore, ink crossings were investigated to demonstrate that ink applied after creation of a document could be differentiated from the originally applied ink.

BaySpec, Inc. has developed a complete line of 1064 nm excitation, dispersive Raman systems that offer maximum reduction in fluorescence interference from biological samples and thus making them very useful tools for biofuel research.

Low concentration natural methanol exists in most alcoholic beverages and usually causes no immediate health threat.

Columnist Fran Adar discusses applications for Raman and FT-IR spectroscopy.

The authors discuss the use of vibrational spectroscopy to differentiate an authentic article from a counterfeit one throughout a product's lifecycle, from component receipt at the site of manufacture, to product receipt by the end user.

The authors discuss the combined use of Raman and FT-IR spectroscopy in fields such as forensic science, biomedical science, catalysis, and polymers.

Infrared (IR) spectroscopy and Raman spectroscopy are very complementary methods. The strongest demand tends to come from applications that require analytical information from a potentially broad range of compounds and functional groups. The global market for combined Raman and FT-IR accounts for a small but growing percentage of both the broader IR and Raman spectroscopy markets.

Manufacturing control of pharmaceutical solids requires routine measurement of content uniformity. Because of the high information content in Raman spectra, it has been considered a candidate technology for making these measurements.

Polymer blends are designed to address the needs of different industries, and in many cases the relationship between structure, morphology, and material properties is indispensable for optimization of material design.

Raman spectroscopy and differential scanning calorimetry (DSC) are powerful techniques in their own right. Combining the two techniques allows one to combine the chemical and structural information of Raman with the temperature and energetic information of DSC. This allows us to develop a greater understanding of the material. Applications from polymeric and pharmaceuticals are discussed as examples of how this can help the analyst.
The authors discuss the use of a field-deployable Raman instrument for rapid identification of chemical and biological pathogens.

Miniature spectrometers revolutionized the spectroscopy market more than 15 years ago and became a key factor in the creation and steady growth of the photonics field. Today these spectrometers are becoming an important part of the new market of field-deployable analytical instruments used for materials identification based on Raman spectroscopy. Just as before, these spectrometric photonic engines are key factors on reducing the cost and improving the flexibility of applications of a traditionally expensive and rigid vibrational spectroscopy method. Raman spectroscopy is becoming an affordable tool used for applications ranging from homeland security to green energy research and development, either at a laboratory, a crime scene, or a biodiesel manufacturing facility.

There are many situations in which it would be highly desirable to apply the benefits of Raman to larger volumes of solid material such as powders, tablets, and composites. Raman benefits such as minimal sample preparation, the ability to provide rich information on both organics and inorganics, and its ability to measure through glass and plastic packaging make it highly amenable to these kinds of samples.

New research being conducted at the University of Arkansas is demonstrating that Raman spectroscopy can be used to detect and monitor circulating carbon nanotubes in vivo and in real time.

The authors discuss the use of Raman spectroscopy to identify an unknown gem or mineral sample or to verify that a known sample has been classified correctly.

This article discusses instruments that can be used in the field to rapidly and accurately identify various explosives and their precursors.

In this article, columnist Fran Adar will review the important features of the Raman spectra of these materials and indicate why the extracted information is important for material development and engineering.

Columnist Fran Adar discusses the physical determinants of spatial resolution and developing methods to improve the mapping speeds of Raman images.

The authors discuss the use of instruments that combine FT-IR and Raman microscopy on a single platform, enabling synergistic studies of many materials.